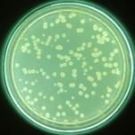

з§ӢиЎҢеҶӣиҷ«еҚөе·ўз»ҶиғһSf9е…ӢйҡҶж Әз»Ҷиғһеҹ№е…»зҡ„дјҳзӮ№

з§ӢиЎҢеҶӣиҷ«еҚөе·ўз»ҶиғһSf9е…ӢйҡҶж Әз»Ҷиғһеҹ№е…»зҡ„дјҳзӮ№пј?з ”з©¶зҡ„еҜ№иұЎжҳҜжҙ»з»ҶиғһеңЁе®һйӘҢиҝҮзЁӢдёӯпјҢж №жҚ®иҰҒжұӮеҸҜе§Ӣз»ҲдҝқжҢҒз»Ҷиғһжҙ»еҠӣпјҢ并еҸҜй•ҝж—¶й—ҙзӣ‘жҺ§гҖҒжЈҖжөӢз”ҡиҮіе®ҡйҮҸиҜ„дј°дёҖйғЁеҲҶжҙ»з»Ҷиғһзҡ„жғ…еҶөпјҢеҢ…жӢ¬жҙ»з»Ҷиғһзҡ„еҪўжҖҒгҖҒз»“жһ„гҖҒз”ҹе‘Ҫжҙ»еҠЁзӯүгҖ?.з ”з©¶жқЎд»¶еҸҜд»ҘдәәдёәжҺ§еҲ¶pHгҖҒжё©еәҰгҖҒж°§ж°”гҖҒдәҢж°§еҢ–зўігҖҒеј еҠӣзӯүзү©зҗҶеҢ–еӯҰзҡ„жқЎд»¶пјҢеҸҜд»Ҙж №жҚ®е®һйҷ…йңҖиҰҒиҝӣиЎҢдәәдёәзҡ„жҺ§еҲ¶пјҢеҗҢж—¶пјҢеҸҜд»Ҙж–ҪеҠ еҢ–еӯҰгҖҒзү©зҗҶгҖҒз”ҹзү©зӯүеӣ зҙ дҪңдёәжқЎд»¶иҖҢиҝӣиЎҢе®һйӘҢи§ӮеҜҹпјҢиҝҷдәӣеӣ зҙ еҗҢж ·еҸҜд»ҘеӨ„дәҺдёҘж јжҺ§еҲ¶д№ӢдёӢгҖ?.з “ь/div>
2022.10.12
з»өзҫҠиЎҘдҪ“зүҮж®ө3bеҸ—дҪ“ELISAиҜ•еүӮзӣ’ж ·жң¬еӨ„зҗҶеҸҠиҰҒжұӮ


з»өзҫҠиЎҘдҪ“зүҮж®ө3bеҸ—дҪ“ELISAиҜ•еүӮзӣ’ж ·жң¬еӨ„зҗҶеҸҠиҰҒжұӮпј?. иЎҖжё…пјҡе®Өжё©иЎҖж¶ІиҮӘ然еҮқеӣ?0-20еҲҶй’ҹпјҢзҰ»еҝ?0еҲҶй’ҹе·ҰеҸіпј?000-3000иҪ?еҲҶпјүгҖӮд»”з»Ҷ收йӣҶдёҠжё…пјҢдҝқеӯҳиҝҮзЁӢдёӯеҰӮеҮәзҺ°жІүж·ҖпјҢеә”еҶҚж¬ЎзҰ»еҝғгҖ?. иЎҖжөҶпјҡеә”ж №жҚ®ж Үжң¬зҡ„иҰҒжұӮйҖүжӢ©EDTAжҲ–жҹ жӘ¬й…ёй’ дҪңдёәжҠ—еҮқеүӮпјҢж··еҗ?0-20еҲҶй’ҹеҗҺпјҢзҰ»еҝғ20еҲҶй’ҹе·ҰеҸіпј?000-3000иҪ?еҲҶпјүгҖӮд»”з»Ҷ收йӣҶдёҠжё…пјҢдҝқеӯҳиҝҮзЁӢдёӯеҰӮжңүжІүж·ҖеҪўжҲҗпјҢеә”иҜҘеҶҚж¬ЎзҰ»еҝғгҖ?. е°ҝж¶Іпјҡз”Ёж— иҸҢ管收йӣҶпјҢзҰәь/div>
2022.10.05
еҶ·зғӯеҶІеҮ»иҜ•йӘҢз®ұжҖҺд№ҲйҖүжӢ©
жҸҗеҸҠеҶ·зғӯеҶІеҮ»иҜ•йӘҢз®ұж—¶пјҢзӣёдҝЎеҫҲеӨҡдәәйғҪжңүжүҖиҖій—»пјҢжҳҜдёҖз§ҚиғҪеӨҹжөӢиҜ•еҗ„з§Қжқҗж–ҷеңЁжһҒйҷҗжё©еәҰдёӢеҸ‘з”ҹеҸҳеҢ–зҡ„и®ҫеӨҮд»ӘеҷЁпјҢз”ұжӯӨжқҘдәҶи§Јжқҗж–ҷжҖ§иғҪжҳҜеҗҰеҗҲж јпјҢеёёеёёиў«е№ҝжіӣеә”з”ЁеңЁеҗ„дёӘйўҶеҹҹпјҢдҫӢеҰӮз”өеӯҗз”өеҷЁйўҶеҹҹпјҢеЎ‘иғ¶еЎ‘ж–ҷйўҶеҹҹпјҢйҮ‘еұһжқҗж–ҷйўҶеҹҹзӯүпјҢжүҖд»ҘиҜ•йӘҢз®ұеңЁеёӮеңәдёҠзҡ„дҪҝз”ЁйңҖжұӮиҝҳжҳҜиӣ®еӨ§пјҢеҲқж¬ЎжҢ‘йҖүеҶ·зғӯеҶІеҮ»иҜ•йӘҢз®ұпјҢеҲ°еә•жҖҺд№ҲйҖүжӢ©еҘҪзҡ„дә§е“Ғе‘ўпјҹ1гҖҒиҰҒжғізҹҘйҒ“д»Җд№ҲжҳҜеҶ·зғӯеҶІеҮ»иҜ•йӘҢз®ұпјҹеҶ·зғӯеҶІеҮ»иҜ•йӘҢз®ұпјҢеҸҲеҸ«й«ҳдҪҺжё©еҶІеҮ»иҜ•йӘҢз®ұпјҢеҲҶдёәдёӨз®ұејҸе’Ңдёүз®ұејҸпјҢдҪҝз”Ёз®ұдҪ“ж—¶иў«жөӢж ·е“ҒеҸҜеңЁ
2022.09.30
ж»Өзӯ’йҷӨе°ҳеҷЁжңүе“ӘдәӣдјҳзӮ№
ж»Өзӯ’йҷӨе°ҳеҷЁзҡ„ж°”жөҒеҲҶеёғеҫҲйҮҚиҰҒпјҢиҖғиҷ‘еҰӮдҪ•йҒҝе…Қи®ҫеӨҮеӨ„з”ұдәҺйЈҺйҖҹиҫғй«ҳйҖ жҲҗеҜ№ж»Өж–ҷзҡ„й«ҳзЈЁжҚҹеҢәеҹҹгҖӮж°”жөҒеҲҶеёғжқҝз”ЁдәҺж»Өзӯ’ејҸйҷӨе°ҳеҷЁжңүиҰҒжұӮпјҢж°”жөҒеҲҶеёғеҚҒеҲҶзЁіе®ҡе’ҢеқҮеӢҫгҖӮжүҚжңүеҲ©дәҺж°”жөҒзҡ„дёҠеҚҮе’ҢзІүе°ҳзҡ„дёӢйҷҚпјҢж°”жөҒеҲҶеёғжқҝејҖеӯ”зҺҮ35%.ж №жҚ®и®Ўз®—пјҢйҳ»еҠӣзі»ж•°пјң2,з”ұжӯӨеҸҜи§ҒеңЁж°”жөҒйҖҹеәҰпј?.8m/sзҡ„жғ…еҶөдёӢпјҢеӨҡеӯ”ж°”жөҒеҲҶеёғжқҝеҸҜд»Ҙж»Ўи¶іж»Өзӯ’ејҸйҷӨе°ҳеҷЁзҡ„иҰҒжұӮгҖӮж»Өж–ҷжҳҜж»Өзӯ’ејҸйҷӨе°ҳеҷЁж ёеҝғйғЁеҲҶпјҢд№ҹжҳҜж»Өзӯ’ејҸйҷӨе°ҳеҷЁжҲҗиҙҘзҡ„е…ій”®пјҢиҝҮеҺ»з”Ёзҡ„ж»Өж–ҷдёҖиҲ¬йғҪз”ЁзәёйЎөзәӨз»ҙж»Өж–ҷиҝҷз§Қж»Өж–ҳь/div>
2022.09.26
дҪҺжң¬еә•ОұОІжөӢйҮҸд»ӘеҲ»еәҰжөҒзЁӢ
1гҖҒз”ЁеӨ©е№із§°еҸ–160mgзҡ„Am241(Оұж ҮеҮҶжә?е’ҢK40(ОІж ҮеҮҶжә?еҗ?д»ҪеңЁж ·е“ҒзӣҳдёӯгҖ?гҖҒеңЁз§°еҸ–зҡ„ж ҮеҮҶжәҗдёӯеҠ е…Ҙй…’зІҫпјҢз”ЁзҺ»з’ғжЈ’е°Ҷе…¶й“әеқҮеҢҖпјҢеҰӮжһңйў—зІ’иҫғеӨ§еҸҜз”ЁзҺ»з’ғжЈ’е°Ҷе…¶зўҫз»ҶгҖ?гҖҒе°Ҷй“әеҘҪзҡ„ж ҮеҮҶзү©иҙЁж”ҫеҲ°зәўеӨ–зҒҜжҲ–е№ІзҮҘз®ұйҮҢзЁіе®?0В°дёӢзғҳзғӨеӨ§зә?0еҲҶй’ҹе·ҰеҸіеҚіеҸҜгҖ?гҖҒе°ҶеҲ¶дҪңеҘҪзҡ„ж ҮеҮҶзү©иҙЁAm241ж”ҫеҲ°д»ӘеҷЁж ·е“ҒжөӢйҮҸжҠҪзӣҳдёӯгҖ?гҖҒжү“ејҖд»ӘеҷЁпјҢеҸҢеҮ»жЎҢйқўзЁӢеәҸеӣҫж ҮгҖ?гҖҒи®ҫзҪ®еҘҪжөӢйҮҸеҸӮж•°гҖҒжөӢйҮҸе‘ЁжңҹгҖҒжөӢйҮҸж—¶й—ҙгҖ?гҖҒзҪ®йҳҲжҲҗеҠҹеҗҺзӮ№еҮ»зЎ®е®ҡгҖ?
2022.09.23
дёҠжө·и…ҫжӢ”иҙЁжһ„д»Әз”ЁдәҺжөӢе®ҡйҫҷе®үжҹҡжҹҡзҡ®зЎ¬еәҰ


иҝ‘ж—ҘпјҢе№ҝе®үиҒҢдёҡжҠҖжңҜеӯҰйҷўз ”究дәәе‘ҳеңЁеӣҪеҶ…жңҹеҲҠгҖҠеҶңдә§е“ҒеҠ е·ҘгҖӢеҸ‘иЎЁдәҶйўҳдёәвҖңйҫҷе®үжҹҡжҹҡзҡ®зЎ¬еҢ–е·Ҙиүәз ”з©¶"зҡ„з ”з©¶и®әж–ҮгҖӮеңЁиҜҘи®әж–ҮдёӯпјҢз ”з©¶дәәе‘ҳеҲ©з”ЁдёҠжө·и…ҫжӢ”Rapid TA+иҙЁжһ„д»ӘжөӢе®ҡйҫҷе®үжҹҡжҹҡзҡ®зҡ„зЎ¬еәҰгҖӮж‘ҳиҰҒпјҡдёәи§ЈеҶійҫҷе®үжҹҡжҹҡеӯҗзҡ®зҡ„жөӘиҙ№й—®йўҳпјҢжҸҗй«ҳжҹҡжһңйҷ„еҠ еҖјпјҢд»Ҙеӣӣе·қе№ҝе®үдә§йҫҷе®үжҹҡжһңзҡ®дёәеҺҹж–ҷпјҢйҖҡиҝҮжё…жҙ—гҖҒзғӯзғ«гҖҒзЎ¬еҢ–зӯүе·ҘиүәпјҢд»ҘзЎ¬еҢ–еүӮиҙЁйҮҸжө“еәҰгҖҒжөёжіЎжё©еәҰе’ҢжөёжіЎж—¶й—ҙдҪңдёәиҜ•йӘҢеӣ зҙ пјҢд»ҘжҹҡеӯҗеӨ–иЎЁзҡ®зЎ¬еәҰе’Ңж„ҹе®ҳиҜ„еҲҶдҪңдёәиҜ„д»·жҢҮж ҮпјҢйҮҮз”ЁеӨҡжҢҮж Ү
2022.09.19
ж¶ІзӣёиүІи°ұд»Әж“ҚдҪңжӯҘйӘӨгҖҒеҺҹзҗҶеҸҠжіЁж„ҸдәӢйЎ№
ж¶ІзӣёиүІи°ұд»ӘиғҪж №жҚ®з”ЁжҲ·йңҖиҰҒжү©еұ•еҗ„з§ҚжЈҖжөӢеҷЁпјҢзҙ«еӨ–гҖҒзӨәе·®гҖҒиҚ§е…үгҖҒи’ёеҸ‘е…үж•Је°„жЈҖжөӢеҷЁзӯүпјҢеҸҜй…ҚзҪ®жүӢеҠЁеҸҠиҮӘеҠЁиҝӣж ·зі»з»ҹгҖӮе№ҝжіӣең°еә”з”ЁдәҺеҢ–е·ҘеҺҹж–ҷеҲҶжһҗпјҢйҘІж–ҷдјҒдёҡгҖҒеҶңиҚҜдјҒдёҡпјҢеӨ§еһӢз”ҹдә§дјҒдёҡдёӯзҡ„з”ҹдә§иҝҮзЁӢжҺ§еҲ¶зӯүйўҶеҹҹгҖӮж¶ІзӣёиүІи°ұд»Әж №жҚ®еӣәе®ҡзӣёжҳҜж¶ІдҪ“жҲ–жҳҜеӣәдҪ“пјҢеҸҲеҲҶдёәж¶?ж¶ІиүІи°?LLC)еҸҠж¶І-еӣәиүІи°?LSC)гҖӮзҺ°д»Јж¶ІзӣёиүІи°ұд»Әз”ұй«ҳеҺӢиҫ“ж¶ІжіөгҖҒиҝӣж ·зі»з»ҹгҖҒжё©еәҰжҺ§еҲ¶зі»з»ҹгҖҒиүІи°ұжҹұгҖҒжЈҖжөӢеҷЁгҖҒдҝЎеҸ·и®°еҪ•зі»з»ҹзӯүйғЁеҲҶз»„жҲҗгҖӮдёҺз»Ҹе…ёж¶ІзӣёжҹұиүІи°ұиЈ…зҪ®жҜ”иҫғпјҢе…·жңүй«ҳж•ҲгҖ?/div>
2022.09.16
| еҲ…ьspan class='rednum'>84йЎөпјҢеҪ“еүҚз¬?span class='rednum'>16йЎҙьdiv class="fyclass">1...121314151617181920...84 |
 m.cnreagent.com
m.cnreagent.com












